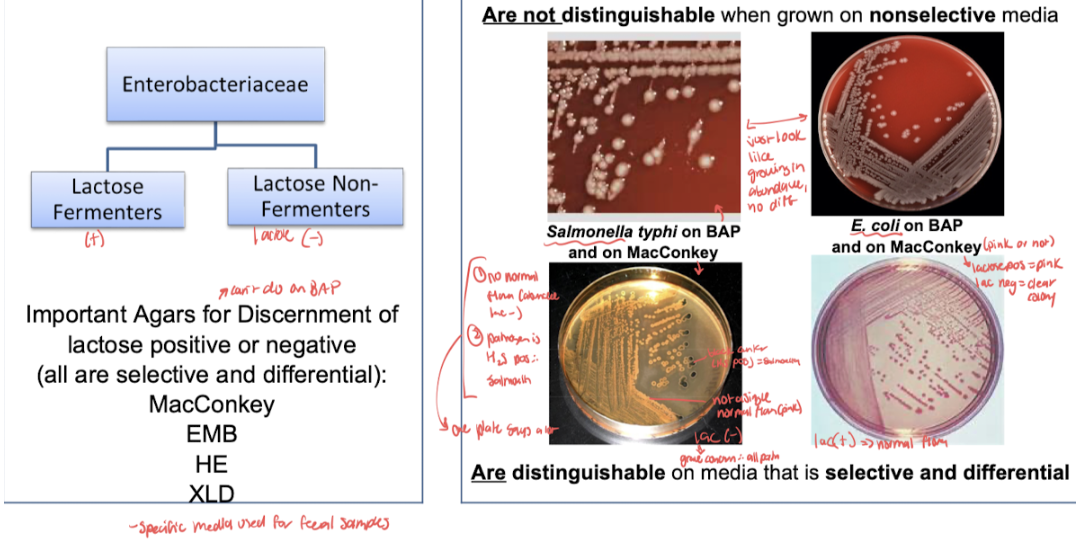

1/96
Looks like no tags are added yet.
Name | Mastery | Learn | Test | Matching | Spaced | Call with Kai |
|---|
No analytics yet
Send a link to your students to track their progress
Enteric=
family, genus, or species level
relating to or occurring in the intestines (family is composed of several genre)
Opportunistic Enterobacteriaceae=
cause disease? or normal flora?
found where
predom reside where
commonly referred to as ___ bac bc of where they reside
Most enterics do not cause disease when confined to the intestinal tract of a normal host, therefore are nonpathogenic→many are normal flora of intestines; however, if given an environment where there is a dysfunctional host response or an opportunity to invade other body sites, many enterics have the capability of producing disease in any tissue.
“Opportunisitic pathogens” like E. coli getting into urinary tact
Found in soil, water, decaying matter semicolon test by cultures, the major indicator of cleanliness and water is number of E. coli per milliliter
composed of a large number of closely related bacterial genre and species that inhabit the lower alimentary canal, which is predominantly the intestinal tract of man as normal flora
because of their normal habitat and man, they have been referred to as enteric/intestinal bacteria
Enteropathogenic enterobacteriaceae=
why important to man
salmonella is causitive ag of __
shigella—
yersina—
some members of enteric bac group are among the most important intestinal pathogens of man such as salmonella– causative agent of typhoid fever, shigella-- bacillary dysentery, Yersina– the plague
at sites external to GI, enterobac are
Enterobacteriaceae can be pathogenic at sites external to the GI tract
Can be normal flora, but become pathogens if enter external sites
E. coli
e stands for
O2 met
normal flora? what % of time
opportunistic or pathogenic (5 diseases can or does cause)
lactose __=strains of concern
can produce___toxin
sero strain ___:__ “enterohemorrhagic E.coli” or EHEC—>2 antigens used to ID
(E=escherichiaeae genus→Escherichia coli)
Predominant facultative organism that makes up the normal flora (95% of the time) of the large intestine
opportunistic enteric rod that can cause intestinal as well as extraintestinal infections
UTI, gram neg sepsis, meningitis, wounds, pneumonia
Lactose neg strains of of concern
Can produce enterotoxin
Can be the serologic strain O157:H7 (O antigen and H antigen so flagella and gram neg cell wall LPS)
“Enterohemorrhagic E. coli” or EHEC
other pathogenic strains of E. coli (4)
if toxin is prob, fever or no?
all are lactose __
symptom progression
Can be other pathogenic strains: all have diff numbers after O157:__
EPEC (enteropathogenic E. coli)
ETEC (enterotoxic E. coli)
EIEC (enteroinvasive E. coli)
EaggEX (enteroaggregative E. coli primarily causing chronic diarrhea in HIV patients)
If toxin is a problem (EHEC, ETEC) no fever present, if just infection (EIEC, EPEC) fever present
All are lactose neg
ingestion, then 3-4s before symps of abdominal cramps and nonbloody diarrhea, then 1-2 days until bloody diarrhea, the 5-7 days until resolution (95%) or HUS – hemolytic uric syndrome (5%)-->more treatment needed
Shiga-toxin producing E. coli O157:H7 (EHEC):
important where geo
endo or exotoxin
disease comp 0157:H7 is dev of ___, which results…% death and …%____disease
transmitted primarily by
toxin effects on blood vessels/body
Important pathogen in North America
produces Shiga toxin (exotoxin) which is the same toxin as in produced by shigella dysenteriae hence the name
most important disease complications of E coli 0157:H7 is development of hemolytic uremic syndrome (HUS)
occurs in 5 to 10% of patients with the strain and results in 5% death or 30% chronic renal disease
Infection is transmitted primarily by food, water, direct contact with bacteria like swimming in contaminated water
implicated food products are ground beef, salami, raw milk, Alfalfa sprouts, unpasteurized apple cider and apple juice, contaminated pork, poultry, lamb, bagged fresh spinach
toxin damages capillary lining→ platelets clump in the area to stop blood loss and initiate healing →platelets form mesh and capillaries causing damage to RBCs which prevents adequate blood flow to affected organs→ results in organ dysfunction or failure due to 85% occlusion of blood vessel
lab ID of Shiga-toxin producing E. coli O157:H7 (EHEC)—>3 ways (2 assays
Lab ID is easily performed with specialized media,
PCR (for fast turnaround time),
agglutination reactions (that are antibody-antigen assays), enzyme linked immunosorbent assay (ELISA) testing stool culture→ using antibody against toxin specifically to ID antigen in stool specimen
Treatment of E.coli clinical infections: (antibi and symp management)
Antibiotics (E.coli susceptible to most but some rez emerging)
Fluid and electrolyte management is best treatment of diarrhea→replacing is of gravest concern and usually if done properly will ensure full recovery
Name the most common extraintestinal infection caused by organisms from the family Enterobacteriaceae.
UTI (90%)
Name the most common cause (genus, species) of urinary tract infection.
normal flora where
sero strain most common
lactose test
toxin prod
E. coli (E=escherichiaeae genus→Escherichia coli)
Predominant facultative organism that makes up the normal flora (95% of the time) of the large intestine
opportunistic enteric rod that can cause intestinal as well as extraintestinal infections
UTI, gram neg sepsis, meningitis, wounds, pneumonia
Lactose neg strains of of concern
Can produce enterotoxin
Can be the serologic strain O157:H7 (O antigen and H antigen so flagella and gram neg cell wall LPS)
“Enterohemorrhagic E. coli” or EHEC
5. Relating to Enterobacteriaceae in general:
a. Describe the Gram stain morphology
b. Describe determinants of pathogenicity in the family Enterobacteriaceae. (4)
a. gram neg rod
b. Some have capsules, flagella, LPS or endotoxin, enterotoxin (usually w/ food poisoning)
Name 7 biochemical properties common to ALL genera within the family.
gram stain, O2 use, CTA sugars, oxidase, nitrate, spore formation, lactose tests
name of test strips that can do many biochem rxns at once
Are gram-negative rods in a Gram stain
are facultative anaerobes (either for O2 req)
utilize a glucose fermentatively with release of acid and products (glucose pos in CTA sugar test)
are oxidase negative– lack cytochrome oxidase (all Neisseria is pos)
are nitrate positive– reduces nitrates to nitrites
do not produce spores
*lactose neg (lactose fermenters/pos being nonpathogenic strains of enterobac/ normal flora→ pink on MacConkey agar)= is only true for pathogenic intestinal tract bac, not other locations
Can use API strips to test many diff reactions
Name the key biochemical property, which distinguishes pathogenic intestinal (enteric) bacilli from normal flora intestinal (enteric) bacilli.
(4 selective/differential media used)
Lactose fermentation: pathogens all don’t ferment lactose (Macconkey, EMB-eosin methylene blue, HE-hektoen enteric, or XLD-xylose lysine deoxycholate agar are selective and differential media to show this)
List the three major components of the enteric bacterial cell that are used in serological typing. Describe serological typing of bacteria to include isolates that are usually typed using this method and why typing is important.
3 antigens used
analogous to what subspeciation typing
why important
Analogous to bacteriophage typing performed on staphylococcus, enteric bacterial pathogens are subspeciated using serological or antibody based typing
this typing is especially useful for salmonella, shigella, shiga toxin producing E. coli, yersinia, campylobacter, vibrio (salmonella ID by O serotyping→pos for O and H antigen means agglutination/pos on macro agglutination test)
Serotyping of enteric pathogens is important for epidemiology and classification purposes
Antigens used:
K–Capsular or polysaccharide antigen, only used if bacteria produces capsule, best known as Vi antigen of salmonella typhi (has role in pathogenesis of typhoid fever)
H–Flagella or protein antigen, species bacteria and genre salmonella and Arizona
O–Somatic (relating to the body) antigen, use for epidemiologic serological subgrouping, lipopolysaccharide (LPS) also known as o antigen in the bacterial cell wall is in LPS endotoxin of gram-negative bacteria
Endotoxin:
definition
% patients develop shock and mortality rate range
3 symps/disease states in the progression of effects of endotoxin
why does it lead to diff consequences?
3 consequences of toxin due to inflam response
LPS (gram neg) toxin released upon cell death
30% of patients with enteric septicemia will develop shock with 40 to 90% mortality
mechanism of endotoxin effects are not completely elucidated, however, the defect is inadequate blood supply to vital organs which causes
hypoxia - oxygen deficiency in the tissue
metabolic failure - failure of a metabolic process, maybe limited to lungs for example or one other organ
multiple organ failure - current leading cause of death and intensive care units, more organs involved means worse prognosis for patient, follows metabolic failure of one organ usually
Activates inflammation in multiple different ways which can lead to many different consequences ultimately leading to fever, disseminated intravascular coagulation/DIC (clotting of vasculature over the body), shock
Enterotoxins
def
specific for cells in the ___that cause…
___can be used for identification
2 virulence factors in addition
exotoxin that affects intestinal tract (gram pos or gram neg can have)
toxins specific for cells in the intestinal mucosa that cause gastrointestinal upset such as cramps, diarrhea, and nausea
exert the toxic effect on the intestinal tract:
cause transudation into the ilium (that is, passage of fluid through a membrane or tissue surface to the ileum, a region between the small and large intestines)
results and diarrhea and vomiting
serologic antigens specific for the enterotoxin, can be used for identification
capsules and biofilms
Define the terms selective, non-selective, enriched and differential in terms of culture media and cite examples of each.
nonselective vs selective exs
At sites external to the GI tract but with enterobacteriaceae, these samples are inoculated onto general, enriched (if not abundant yet to enhance growth of pathogen), selective and/or differential media depending on the location of the body from which the sample was taken
Enterobacteria from fecal samples need to be differentiated from one another since the GI tract has a lot of normal bacteria flora, many of which belong to this family
and enterobacteria normal flora and pathogenic are not distinguishable when grown on nonselective (BAP) media–all look same
Pathogenic bacteria and stool samples are all lactose negative so microbiologists look for lactose negative colonies
MacConkey agar: not pink is lactose pos (pathogen) and if H2S pos, salmonella bc only one that is→ one selective and differential media plate can give lots of info)
Describe the morphology of Shigella and Salmonella when Gram stained.
Gram neg rod
State the disease caused by Shigella and identify which species cause the disease.
All species cause bacillary dysentery (shigellosis)
all Shigella specices are human_____(normal flora or pathogens)
pathogens
Shigella species diff (2 ways)
Shiga’s bacillus
Boyd’s bacillus
Flexner’s bacillus
Sonne-Duval bacillus =>___% of shigella reported in US
(include letter of species type)
Species are differentiated serologically and biochemically:
S. dysenteriae (A)- Shiga’s bacillus
S. boydii (C)- Boyd’s bacillus
S. flexneri (B)- Flexner’s bacillus
S. sonnei (D)- Sonne-Duval bacillus =>60-80% of shigella reported in US
Diff letters are from typing of species
Clinical infection shigella (all species cause 2 things, source, transmission)
All shigella species cause severe diarrhea and bac dysentery
Source is human
Transmission is ingestion of contam food or water
List the three categories of disease caused by Salmonella.
causitive agent, source, transmission, % chronic carriers of most severe form of disease
Enteric fevers are due to salmonella invading extraintestinal tissues
Have typhoid fever as most severe form of disease
Caused by S. typhi
Source=man (only known host for S. typhi)
transmission=fecal/oral route
Occurs when noninfected indiv ingest food or water fecally contam by diseased indiv or carriers
3-5% of typhoid patients (symp or asymp) develop into chronic carriers and are sources of infections for others
Acute gastroenteritis is a type of food associated infection
Septecemia
3 week course of enteric fever (salmonella)
week 2 two phases
WEEK 1 ENTERIC FEVER manifestations: constipation>diarrhea is the rule
During this time, the salmonella are penetrating the intestinal wall, infecting the lymphatic system, multiplying intracellularly in host cells, being carried to the mononuclear phagocyte system (MPS: formerly known as RES) by the bloodstream where phagocytosis occurs in the lymphatics and MPS
WEEK 2: when symp really start manifesting
Bac re-enter the bloodstream, bacteremia dev, bac lyse, endotoxin released, patient becomes severely ill
Fever of 104 deg F (40 deg C)
Delirious
Abdomen is tender
Abdomen has rose colored spots that appear (*unique symp that look for ID and begin to look for how to tret)
Salmonella then reinfects the intestinal tract
Diarrhea
Necrosis (cell death that is so fast, accumulates bc don’t have enough time to remove by normal mech) and sloughing of intestinal lining
Intestinal ulceration develops (open wounds/sores)
WEEK 3:
Patient remains febrile
Patient shows improvement if no complications develop (often do)
COMPLICATIONS: Most deaths associated with typhoid fever are due to complications
complications enteric fever (3)
COMPLICATIONS: Most deaths associated with typhoid fever are due to complications
severe bleeding due to necrosis of blood vessels during the ulceration process
perforation of intestinal wall due to extensive ulceration
Cholecystitis
inflammation of the gallbladder due to presence of salmonella
bacteria may be found in the gallbladder years later
salmonella GASTROENTERITIS manifestations:
when infection occurs after incub
how long symp last
3 symp
most common causative agent
Intestinal infection usually occurring about 18 hr after ingestion of the organism
Since food infection, not food poisoning (faster prez), takes time to replicate
Disease symp are diarrhea, fever, abdominal pain
Usually self-limiting (lasts 2-5 days)
Complications: dehydration, electrolyte imbalance are major threats
All species of salmonella are capable of producing gastroenteritis, however most common agent is salmonella enteritidis ssp typhimurium
salmonella SEPTICEMIA manifestations:
3 symp
complications
causitive agent
Fever, chills (both bloodstream related), anemia (dec RBC)
Complications: lesions develop systematically producing osteomyelitis, pneumonia, pulmonary abscesses, meningitis, endocarditis
Causative agent: salmonella cholerae-suis
Classify Shigella and Salmonella on the basis of lactose fermentation.
Since both are pathogenic enteric species, both are lactose negative
Discuss the relationship of somatic (O) antigen and capsular (K) antigen in the serologic typing of Shigella and Salmonella.
what antigen is used in typing
All shigella possess O antigen (LPS endotoxin from gram neg): some possess K (capsular) antigen
only O antigen is used in shigella typing
Describe antigen interference in terms of capsular (K) antigen in Shigella.
false__ test for antigens
Antigen interference: K antigen is not significant in typing shigella but may mask the O antigen (somatic) and therefore must be removed from typing
Sticky K antigen therefore can cause pos antigen testing for O when there is not (false pos)
Describe how one would proceed in typing Shigella despite the presence of antigen masking.
→K antigen is heat labile and O is heat stable so boiling bac suspension removes the K antigen interference so that typing for O can be done
Name the most common causative agent (genus, species, serotype) of Salmonella food infection.
Tribe: salmonelleae
Salmonella, Citrobacter, Arizona were formally classified as different genre within the tribe→ changes in classification and nomenclature due to DNA sequencing have caused reclassification of the genus Citrobacter into its own tribe Citrobacteriaceae and reclassification of Arizona as subspecies of salmonella
Includes intestinal (enteric) pathogens of the genus salmonella and enteric opportunist of the genre Citrobacter and Arizona
Members of genus salmonella (salmonella, citrobacter, arizona) are causative agents of salmonellosis
Major site of infection is the lining of the intestinal tract
Many strains in this genus has the potential to produce disease
Arizona subgroup of salmonella
how common is it isolated from man
man is ____host
most common symp of Arizonia infect (as well as others)
opportunist or obligate path
Used to be genus on own, now subspecies
Rarely isolated from man
Usually isolated from reptiles and birds
Man is an accidental host, esp of infants or immunocompromised indv
“Opportunist”
Gastroenteritis–one of most common symp of Arizona infect
Perionitis, pleuritis, osteomyelitis, meningitis may be caused but as less common than gastroenteritis
Citrobacter
Two species of med importance:
Both species are causative agents of ___ (most common presentation), and 3 more
C. freundii and C. diversus
Both species are causative agents of UTI (most common presentation), wound infections, bacteremia, meningitis (pos spinal fluid cultures)
Shigella progression of pathogenesis (4 main steps and is bac found in bloodstream? how does it evade neutrophils)
invasive organism (not toxin so fever)
Shigella is an invasive bacteria that enters a small intestine where it multiplies
it then proceeds to the mucus surface of the terminal ileum and colon
bacteria multiply in the epithelial cells
it invades the epithelial cells where it resides and causes abscess formation and sloughing of epithelial cell lining leading to cell death
a local inflammatory response would be activated– part of the inflammatory response includes neutrophil infiltration which explains the presence of neutrophils and patient stool samples
spontaneous cure / self-limiting disease progression may occur within 2 to 7 days
patients may succumb to the disease if not well-managed– especially in infants and elderly
Enter epithelial cell in intestinal tract
Multiply inside cell (where safe from immune response)
Invade neighboring epithelial cells and evades immune defense (can proceed to inc distance across entire intestinal tract)
An abscess forms (cells falls apart) as epithelial cells are killed by the infection
The bac rarely spread into the blood stream
Since intracellular travel is not needed, can evade immune cells like neutrophils
S. Aureus: mechanism of poisoning
when symps appear and 3 symps
is ingestion of food contaminated during preparation or storage
bacteria grow and release enterotoxin into food, doing all the damage like with toxic shock syndrome
toxin is performed when ingested
symptoms appear to 8 hours after ingestion (some bac but lots of toxin); GI symptoms of vomiting and diarrhea, headache typically
Salmonella: invasiveness, intracellular viability, toxins (2)
Invasiveness
Like shigella, invades the epithelial lining but does not reside in the epithelial lining and instead penetrates (goes through) the epithelial lining into subepithelial tissue
Intracellular viability
After invasion, the bac are ingested by macrophages where they multiply and pass to other body sites
The ability to survive intracellularly is due to specific surface O antigens or in the case of salmonella typhi, the presence of Vi (virulence) capsular antigen
S. typhi presence of Vi antigen makes more virulent than those without→Vi anti prevents intracellular destruction of the bac by phagocytic cells (protective virulence factor)
Endotoxins
Upon destruction of the salmonella, endotoxin (gram neg O antigen LPS) is released and responsible for fever and shock manifested during salmonella septicemia
enterotoxins
Have cytotoxic (cell killing) and enterotoxic (intestinal poisoning) properties
Patients infected with salmonella strains producing enterotoxin have inc fluid loss and inc inflam components
Incubation period
Shigella–
S. aureus–
Salmonella–
Shigella–2-3 days
S. aureus–symptoms appear to 2-8 hours after ingestion (some bac but lots of toxin);
Salmonella– 18 hrs
Fever?
Shigella–
S. aureus–
Salmonella–
Shigella–fever
S. aureus–no fever
Salmonella–fever
Symptoms
Shigella–
S. aureus–
Salmonella–
what is usually present in addition in salmonela (in terms of WBC)
Symptoms
Shigella– appear abruptly, fever, abdominal pain, cramps, bloody diarrhea with mucus, usually neutrophils (WBC response)-->serious concern and occurs last in progression; electrolyte imbalance and dehydration can be life threatening
S. aureus–GI symptoms of vomiting and diarrhea, headache typically
Salmonella–Is an acute infection with continuous fever, skin eruptions, bowel disturbances, toxemia (toxic prod in blood)
Leukopenia (dec WBC) is usually present
Name the most common species of Shigella isolated in the United States.
S. sonnei (D)- Sonne-Duval bacillus =>60-80% of shigella reported in US
Causative agent
Bac dys:
Typhoid fever: (one primarily to man and one for animals)
how spread
Bac dys: all shigella species
Typhoid fever: salmonella that primarily affects man (human is only natural host/carrier of)=S. Typhi (salmonella enteritidis ssp typhimurium)
Common to man but limited patho in animals
Salmonella that primarily affects lower animals but CAN prod disease in man= S. enterica ssp enterica
Presence of salmonella in habitats other than the natural hosts (water, food, natural env) is explained by presence of fecal contam from infected animals
Determinants of pathogenicity bac dysentry vs thyphoid fever
toxins (1 for bac dys 2 for salmo)
relation to epithelial cell invasion
Bac dys: Shigella is an invasive bacteria that enters a small intestine where it multiplies
it then proceeds to the mucus surface of the terminal ileum and colon
bacteria multiply in the epithelial cells
it invades the epithelial cells where it resides and causes abscess formation and sloughing of epithelial cell lining leading to cell death
a local inflammatory response would be activated– part of the inflammatory response includes neutrophil infiltration which explains the presence of neutrophils and patient stool samples
spontaneous cure / self-limiting disease progression may occur within 2 to 7 days
patients may succumb to the disease if not well-managed– especially in infants and elderly
shiga toxin that is type of enterotoxin with cytotoxic effects
Summary:
Enter epithelial cell in intestinal tract
Multiply inside cell (where safe from immune response)
Invade neighboring epithelial cells and evades immune defense (can proceed to inc distance across entire intestinal tract)
An abscess forms (cells falls apart) as epithelial cells are killed by the infection
The bac rarely spread into the blood stream
Since intracellular travel is not needed, can evade immune cells like neutrophils
Typhoid fever/salmonella:
Invasiveness
Like shigella, invades the epithelial lining but does not reside in the epithelial lining and instead penetrates (goes through) the epithelial lining into subepithelial tissue
Intracellular viability
After invasion, the bac are ingested by macrophages where they multiply and pass to other body sites
The ability to survive intracellularly is due to specific surface O antigens or in the case of salmonella typhi, the presence of Vi (virulence) capsular antigen
S. typhi presence of Vi antigen makes more virulent than those without→Vi anti prevents intracellular destruction of the bac by phagocytic cells (protective virulence factor)
Endotoxins
Upon destruction of the salmonella, endotoxin (gram neg O antigen LPS) is released and responsible for fever and shock manifested during salmonella septicemia
enterotoxins
Have cytotoxic (cell killing) and enterotoxic (intestinal poisoning) properties
Patients infected with salmonella strains producing enterotoxin have inc fluid loss and inc inflam components
Source (reservoir)
Bac dys:
Typhoid fever/salmonella: (man/animal)
Source (reservoir)
Bac dys: humans
Typhoid fever/salmonella: man→s. typhi/animal→s. Enterica fecal contam of water, food, env
Method of transmission
Bac dys:
Typhoid fever/salmonella: (risk group)
bac dys: human to human
Reservoirs are human carriers who shed the bac in their feces
Spread via flies, fingers, food, and water
Typhoid fever/salmonella: ingestion of fecally contam food/water
Anyone can get–greatest risk is for travelers visiting countries where the disease is common
Chronic carrier state exists for salmonella infect
Infected host may have disease (+symp)
May have infection but be asymptomatic
May be chronic carrier: carrier stage varies from days to years; 3% of cases become lifelong carriers
Best patient specimen to use for testing
Bac dys:
Typhoid fever/salmonella:
Lab diag:(1—2 places and when to get specimin)
Sero typing: epidemiology studies (2)
Bac dys: rectal swab of an ulcer taken by sigmoidoscopic examination (similar to colonoscopy)
Typhoid fever/salmonella:
Lab diag:
Biochemical tests
Isolation of salmonella constitutes pos lab diag of salmonellosis
Serological typing may be done to det. Specific strain (sometimes prob in community and want to know commonality)
Appropriate specimen for lab testing dep on stage bc as salmonella dec in blood, goes to inc in stool samples; specimen of greatest interest is where symp appear
If having diarrhea, stool samp (during acute stages of gastroenteritis)
If having fever, blood culture (during septicemia and enteric fevers)
Sero typing: epidemiology studies
Kauffman-White: based on surface antigens
Gives species statues to each antigenic type
Many diff antigenic types (1500-200) based on O and H antigens
Bc number of possible serotypes possible, only large reference centers are capable of typing salmonella isolates
Ewing: used by CDC–3 species of genus salmonella
S. typhi
S. cholerae-suis
S. enteritidis
Clinical infection
Bac dys vs Typhoid fever/salmonella
WBC/bloodstream effects of each
Bac dys: appear abruptly, fever, abdominal pain, cramps, bloody diarrhea with mucus, usually neutrophils (WBC response)-->serious concern and occurs last in progression; electrolyte imbalance and dehydration can be life threatening
Typhoid fever/salmonella:
Is an acute infection with continuous fever, skin eruptions, bowel disturbances, toxemia (toxic prod in blood)
Leukopenia (dec WBC) is usually present
Probs due to depression of white blood cell maturation in the bone marrow and or early release from the bone marrow because of S. typhi
Increase incidents of immature white blood cell and bloodstream leads to inc incidents of immature white blood cell in the blood stream→to not functional/ as functional phagocytosis
WEEK 1 ENTERIC FEVER manifestations: constipation>diarrhea is the rule
During this time, the salmonella are penetrating the intestinal wall, infecting the lymphatic system, multiplying intracellularly in host cells, being carried to the mononuclear phagocyte system (MPS: formerly known as RES) by the bloodstream where phagocytosis occurs in the lymphatics and MPS
WEEK 2: when symp really start manifesting
Bac re-enter the bloodstream, bacteremia dev, bac lyse, endotoxin released, patient becomes severely ill
Fever of 104 deg F (40 deg C)
Delirious
Abdomen is tender
Abdomen has rose colored spots that appear (*unique symp that look for ID and begin to look for how to tret)
Salmonella then reinfects the intestinal tract
Diarrhea
Necrosis (cell death that is so fast, accumulates bc don’t have enough time to remove by normal mech) and sloughing of intestinal lining
Intestinal ulceration develops (open wounds/sores)
WEEK 3:
Patient remains febrile
Patient shows improvement if no complications develop (often do)
COMPLICATIONS: Most deaths associated with typhoid fever are due to complications
severe bleeding due to necrosis of blood vessels during the ulceration process
perforation of intestinal wall due to extensive ulceration
Cholecystitis
inflammation of the gallbladder due to presence of salmonella
bacteria may be found in the gallbladder years later
IMMUNITY: And 90% of the cases, resolution of an attack of typhoid fever provides the patient with lifelong immunity
Serologic diag and graph is useful because can ID when patient is an infection course
In week one there is a large amount of antibodies in the blood culture and low amount in stool and urine samples
Bacteria in blood stream→ decrease antibodies in blood, increase antibodies in stool and urine→ increase antibodies in serum, all other categories go down (stool and urine)→ body recovers from infection because of antibody presence
When antibodies begin to decrease we know that patient has recovered because they are no longer needed to fight the infection
if there are no antibodies / no antibodies decreasing patient might be chronic carrier
salmonella vaccines—2, % effective and agaimst what infection specifically
No salmonella vaccine used in humans is 100% effective, but 2 typhoid vaccines available in the US
Ty21a sold as Vivotif Berna: made by swiss serum and vaccine institute
ViCPS sold as Typhim Vi: made by pasteur merieux
Treatment
Bac dys: 3
Typhoid fever/salmonella:
Uncomplicated gastroenteritis:
Enteric fever or septicemia: (2—sus testing why)
major threats to complications
Bac dys: Since disease is self-limiting, frequently no treatment is sought
ampicillin, tetracycline, chloramphenicol
Fluid and electrolyte balance may be needed depending on severity of disease
Typhoid fever/salmonella: Usually self-limiting (lasts 2-5 days)
Complications: dehydration, electrolyte imbalance are major threats
Uncomplicated gastroenteritis:
Self limiting, manage fluid and electrolyte balance
Antibiotic therapy may prolong the carrier state and help promote rez strains
Enteric fever or septicemia:
Ampicillin or chloramphenicol are drugs of choice
Sus testing needed to ID rez strains
Prevention
Bac dys:
Typhoid fever/salmonella:
Prevention
Bac dys: Sanitation consists of proper sewage disposal, water purification/chlorination, identification and treatment of carriers, carriers should not be allowed to handle food (no restaurant work or food processing)
Typhoid fever/salmonella: No salmonella vaccine used in humans is 100% effective, but 2 typhoid vaccines available in the US
Ty21a sold as Vivotif Berna: made by swiss serum and vaccine institute
ViCPS sold as Typhim Vi: made by pasteur merieux
Prevention/control:
Detection and treatment of carriers–esp those w/ S.typhi
Control of transmission
Sanitation
Proper handling of food (refrigeration and proper cooking)
Describe “carrier state” relevant to a disease. Identify an organism that can produce the carrier state. Discuss the importance of carrier states.
In 1907, Mary Mallon, aka Typhoid Mary, became the first American carrier to be identified– before her, didn't realize concept of carrier who can have infection with no symptoms
Mallon’s employment history was traced back to 1900s and was identified that typhoid breakouts followed her from job to job→ knew that she was the link, didn't know how
from 1900 to 1907 (no handwashing regularly)Mary worked at seven jobs in which 22 people became ill with typhoid fever, including one girl who died shortly after she came to work for them as a cook
Mary resisted accusations that she was the cause of people getting sick and dying and stated that she never had typhoid
finally she consented to a test for typhoid and typhoid bacilli was done for stool samples
typhoid/salmonella is not the only infection with a carrier component
Discuss the different classification schemes of Salmonella based on serologic typing. Name the scheme used and the 3 species identified by the Centers for Disease Control and Prevention.
Ewing: used by CDC–3 species of genus salmonella
S. typhi
S. cholerae-suis
S. enteritidis
Name (genus, species) the predominant facultative microbe in the intestine.
2. Describe the morphology of Enterobacteriaceae when Gram stained.
3. Classify E. coli on the basis of lactose fermentation.
4. Describe mechanisms by which E. coli may cause diarrhea.
Escherichia coli
2. Gram neg rod
3. If pathogenic strain, lactose neg
4. Enterotoxins–specific toxin for cells of intestinal mucosa that cause GI upset
travelers dirrhea type
shiga-like toxin prod
infantile and childhood diherhea
enterotoxin
of these choices: ETEC, EPEC, EHEC
ETEC
EHEC
EPEC
ETEC
Name the pathogenic E. coli and describe their pathogenic effects.
EHEC (___)-->EHEC ____
EPEC (____)
ETEC (____)
EIEC (_____)
EaggEc (_____)→ primary cause of ___in ____ patients
EHEC (enterohemorrhagic)-->EHEC O157:O7
EPEC (enteropathogenic)
ETEC (enterotoxigenic)
EIEC (enteroinvasive)
EaggEc (enteroaggregative)→ primary cause of chronic diarrhea in HIV patients
Describe and discuss Shiga toxin; include organisms from which it is found, pathologic states it causes.
occurs in ___% patients with what strain of E. coili and results in what % death and % renal disease
implicated food prods
toxin damages what, how
lab ID (3)
Shiga-toxin producing E. coli O157:H7 (EHEC):
Important pathogen in North America
produces Shiga toxin (exotoxin) which is the same toxin as in produced by shigella dysenteriae hence the name
most important disease complications of E coli 0157:H7 is development of hemolytic uremic syndrome (HUS)
occurs in 5 to 10% of patients with the strain and results in 5% death or 30% chronic renal disease
Infection is transmitted primarily by food, water, direct contact with bacteria like swimming in contaminated water
implicated food products are ground beef, salami, raw milk, Alfalfa sprouts, unpasteurized apple cider and apple juice, contaminated pork, poultry, lamb, bagged fresh spinach
toxin damages capillary lining→ platelets clump in the area to stop blood loss and initiate healing →platelets form mesh and capillaries causing damage to RBCs which prevents adequate blood flow to affected organs→ results in organ dysfunction or failure due to 85% occlusion of blood vessel
Lab ID is easily performed with specialized media, PCR (for fast turnaround time), agglutination reactions (that are antibody-antigen assays), enzyme linked immunosorbent assay (ELISA) testing stool culture→ using antibody against toxin specifically to ID antigen in stool specimen
Describe the term “self-limiting” as related to clinical course of infection.
Will resolve on own–no antibiotics needed to resolve infection
State the common name for Klebsiella pneumoniae.
Friedlander’s bacillus
Tribe: klebsielleae
3 types, opportunistic or obligate
leading cause of ___infections
cost commonly isolated member of tribe
3 Predisposing cond
symos
why speutum with blood
Bac in genre are opportunistic pathogens
Klebsiella
Enterobacter
Serratia
Some of these bac have become leading cause of hospital acquired infections in US
Most commonly isolated member of the tribe is Klebsiella pneumoniae
Casuitive agent of pneumonia
Also causes infection at other body sites
2nd most populous enteric genus found in the intestine of man that is a constituent of the normal intestinal flora (Escherichia ranks 1st–E. coli)
Clinical infection of pneumonia (K. pneumo):
K. pneumoniae causes primary pneumonia
Common patients affected are those in debilitated states
Predisposing cond exist: alcoholism, chronic obstructive pulmonary disease (COPD), diabetes mellitis
Seriousness of infection is realized by its high mortality rate (~50% despite treatment w/ appropriate antimicrobics)
Symp: chest pain, fever, shaking, chills, shortness of breath (not enough room in lungs for breath)
Coughing up sputum containing blood is an indication of serious infection→vasculature supplying blood to lungs are bleeding
Symps indicating a med emergency include: high fever, rapid HR, low BP, blue-grey pallor indicative of poor tissue oxygenation, mental confusion/delirium from high fever
Other infections K. pneumo: (other than pneumo)—5, and why one is same for all enterics
Abscess formation (bleeding in sputum) and tissue necrosis of the bronchi occur more often with Klebsiella pneumo more than w other bac pneumonia
Besides primary pneumo, K. pneumo has been opportunistically associated w/ UTI (all enterics bc close prox to stool tract), wound infections, septicemia, meningitis
Treatment K. pneumo:
what is Klebsiella usually rez to (2)
why might sus be needed
Antimicrobics are warranted in klebsiella infections
Sensitivity testing needs to be performed to assure appropriate antimic regime indicated (may be ESBL/ extended spec beta-lactamase bac or other emerging microbe of concern)
Not evident if EBSL so must do special testing
Klebsiella pneumo is usually resistant to ampicillin and carbenicillin (via R-factor plasmids)
Classify Klebsiella pneumoniae on the basis of lactose fermentation.
Since normal flora of intestinal tract, lactose pos
Relate predisposing debilitating factors to a primary pneumonia caused by Klebsiella.—3
mortality rate
K. pneumoniae causes primary pneumonia
Common patients affected are those in debilitated states
Predisposing cond exist: alcoholism, chronic obstructive pulmonary disease (COPD), diabetes mellitis
Seriousness of infection is realized by its high mortality rate (~50% despite treatment w/ appropriate antimicrobics)
Name the enteric organism that produces a red pigment
S. marcescens
Red pigment on plated agar media (no other organism w similar pigment)
In pneumo infection, Cough up red sputum that is not blood but often mistaken as blood
proteeae 3 genre of importance
Proteus
P. vulgaris
P. mirabilis
Providencia
P. alcalifaciens
P. stuartii
P. rettgeri
Morganella
M. morganii
Clinical infections and Lab diag proteeae tribe
opportunistic or obligate path
extraintestinal disease states (4—main one and relation to E.coli)
what is unique ab lab diag on plate
lactose ___
Clinical infections
Constitute normal flora of the intestinal tract
Since proteeae tribe of bac are lactose neg normally (when nonpathogenic), so complete evaluative assessment of these bac in feces samples is necessary
Need to be ruled out as pathogenic bac *exception to rule of lac neg being intestinal pathogens
Like other opportunistic enterobacteriaceae, they cause infections at other body sites
Extraintestinal disease states include:
UTI (members of Proteus genus rank 2nd to E. coli as most common causative agents of UTI)
Wound infections
Pneumonia
Septicemia
Lab diag proteeae tribe
Biochemical testing
Actively motile (swarm)
Are lactose neg
Must be diff from enteric pathogens when culturing stool samples
Can conceal other bac in mixed growth plate so need to isolate out pathogens if multiple
State the major type of infections caused by Serratia marcescens.
why now ___pathogen (opp or obl)—>story from 1950
known to cause 5 infections—>what is main link between them
Serratia genus
Were considered harmless/nonpathogenic and were used to det germicidal efficacy and air current flow in hospitals (all organisms are opportunistic, we may not have recog disease yet)
S. marcescens
In 1950, army used a ship to conduct exp bio attack in san fran bay (op sea spray)--> spread cloud of S. marcescens for purpose of studying offensive possibilities of attacking sea port city with aerosol biowarefare from offshore
Few days later, 11 residents were admin to hosp w/ S. marcescens infect that has never been seen before
In 1969, S. marcescens was recog as a bac marker for studying dissemination of bac aerosols was disct.
are now recog as an opportunistic pathogen associated w/ predisposing factors:
Underlying diseases (primary disease present which can lead to secondary disease due to serratia)
Immunosuppressive treatment (HIV/AIDS patients, organ transplant recipients, chemotherapy)
More pop now
Known to cause infections of the endocardium, blood, wounds, UTI, resp tract
Has emerged as a major cause of hospital acquired (nosocomial) infect
Clinical infection (hosp acquired) S. marcescens:
5
Treatment of infect of S. marcescens: how sus/rez is it
Lab diag S. marcescens:
what testing
unique quality on plate
Clinical infection (hosp acquired) S. marcescens:
Pneumo
Sometimes transmitted by contaminated equipment used for resp care treatments (now all disposible)
Spetecemia
Meningitis
Wound infections
UTIs
Usually associated w/ underlying abnormalities (kidney disease, bladder retention)
instrumentation (contaminated catheter)
Treatment of infect of S. marcescens:
Known for their rez to a wide range of antimics
Sus tests must be performed on each isolate to det appropriate antimicrobial therapy
Lab diag S. marcescens:
Biochem testing
Red pigment on plated agar media (no other organism w similar pigment)
Describe what is meant by the term “swarming” when referring to a cultural characteristic. Name the bacteria that display the “swarming” characteristic.
Lab diag proteeae tribe
Biochemical testing
Actively motile (swarm)
Are lactose neg
Must be diff from enteric pathogens when culturing stool samples
Can conceal other bac in mixed growth plate so need to isolate out pathogens if multiple
"swarming" refers to the rapid, coordinated movement of a population of bacteria across a solid or semi-solid surface. It is a collective, multi-cellular behavior that enables bacteria to spread and colonize new territory faster than individual cells could.
Results in concentric circles around a single center colony

Edwardsielleae tribe
how common infections
The only recognized human pathogen in this tribe
has been isolated from (4)
Edwardsiella tarda= The only recognized human pathogen in this tribe
rare infections
has been isolated from wound infections, gastroenteritis/inflammation of stomach and intestinal lining, sepsis, meningitis
Enterobacter
2 Clinically sig enterobacter specie
Both tend to be o____ pathogens
which associated w/ UTIs
isolated from what 3 locations
Clinically sig enterobacter species= E. cloacae, E. aerogenes
Both tend to be opportunistic pathogens
E. cloacae have been associated w/ UTIs
Both have been isolated from wounds, blood, spinal fluid
3 most important species Yersinia
Y. entercolitica, pseudotuberculosis, pestis
Lab ID Yersina (3)—gram stain morph, wayson stain morph, temp req for optimum growth
biochemical testing, lactose neg on MacConkey agar, Wayson stain
a. Gram stain morphology: gram neg rod
b. Wayson stain morphology: bipolar staining with Wayson stain with safety pin appearance
c. Temperature requirement for optimum growth 4 deg C (refrigerator temp)
Y. entercolitica
source
transmission
pathogenesis (invasion—body part and clinical cond)
occurs most freq in what age group
sensitive or rez to most antimic?
source= intestinal tracts of domestic and wild animals
transmission= fecal-oral route–usually due to food or water contam; occurs animal to person or person to person
Pathogenesis:
Invasion: primarily causes intestinal infection, enters via the oral digestive route with infection in the terminal ilium (near appendix), adheres to and penetrates the ileum causing terminal ileitis, lymphadenitis, and acute enterocolitis
Clinical cond following intestinal infection: erythema nodosum or other skin rashes, polyarthritis (arthritis that moves and presents in several joints), septicemia (less common)
Occurs most frequently in children
Treatment: organism is sensitive to many antibi and usually self limiting (unless immunocomp like blood transfusion patients)
lab diag Y. enterocolitica
specimin best recovered from what samples incubates at what temp
test for ID
isolation how from other species
Specimen: organism is best recovered from stool samples that are incubated at room temp
Isolation: use of cold enrichment media enhances its isolation from patient samps (4 deg C is unique temp to grow at)
Biochem tests: for ID
Briefly describe the symptoms associated with Y. enterocolitica infection in: infants, older children, adults
a. Infants (<2) acute diarrhea, fever
b. Older children (2-15) diarrhea though not as severe as infants, fever, abdominal pain, freq mimics appendicitis (primarily tenderness w/ touching abdom, feeling of intestinal upset, fever)
c. Adults weak primary symptoms: slight fever, abdom pain, polyarthritis, rash lasting up to 4 mo
Relate optimum growth temperature of Yersinia enterocolitica to medical importance for Blood Banks that distribute units of blood for use in patients.
what causes symps of shock and chills
Cases of contam units of blood have been reported (blood donor asymp, but since organism grows at 4 deg C, the temp blood is stored, bac multiply and can cause infection)
Most bac die or halt growth at this temp
When blood unit is infused into a recipient, transfusion reaction occurs with symps of chills and shock due to endotoxin
Medical symptoms of importance
State the disease caused by Yersinia pestis.
Formerly known as Pasteurella pestis, classic species of genus Yersina, causative agent of the plague (black plague)
1st, 2nd, 3rd, and current pandemics/epidemics/occurrences of plague (Y. pestis)
% pop died in second 2 pandemics
History of plague pandemics:
1st documented pandemic was 542 AD and lasted 60 years
2nd pandemic: “black death” in 14th C
Spread through asia, europe, china, india with high mortality
25% of total pops of these countries
European phase (1348-1350)
44% of pop died (40 mil/90 mil)
3rd pandemic: started in 1855
Entire world was affected–including US
Wide reservoir of carriers was established (such as wild rodents like rats)
Current:
Still exists endemically in africa, south america, asia, former USSR
Surge of cases in india (several 100 had, 50 died)-->due to inc pop of rats after monsoon floods
Sporadic cases in US usually result of contact w/ wild or domestic animals
No cases of human to human transmission recorded since 1924
Recent epidemic in madagascar (place regularly outbreaks but less dangerous version)-->rats to humans by fleas
In US most incidences are in SW/ cali
how is Y. pestis same from tribe (morpho, 2 stains, lactose) and how diff (media)
Same as tribe:
gram neg rods (coccobacilli)
Bipolar staining w/ wayson’s stain
Lactose neg
Diff from tribe members: grows on ordinary media at 37 deg C→cold enrichment media is not needed
y. pestis immuity and antibi of choice
vaccination?
Survivors have life long immunity
treatment=antimic of choice is streptomycin
Vaccination is rec for lab and field personnel working w/ organism, researchers, peace corp volunteers working in regions where endemic
Not common disease in general pop so not widely used vaccine
Explain the (2 which hinted below) mechanisms by which Y. pestis is transmitted to man, including the major source of the organism.
#s
hosts
Highly pathogenic for many animals: number of bac req to initiate infection is small (3-50 bac cells)
Exists naturally in many animal hosts
Transmission is a cycle of hosts: Y. pestis
3
Reservoir hosts harbor organism but have no sign of disease–can be long term reservoirs (like for whole life)
Do not develop disease
Rodents like mice and voles
Spread bac to other mammals (amplifying hosts)
Amplifying hosts become infected, have disease, die (massive die-offs is way to recog this stage)
Massive die offs occur during epidemics
Rats, ground squirrels, chipmunks, rabbits
Accidental hosts become infected via amplifying hosts (humans)
Become infected by receipt of organism from flea bite, handling infected animals, animal skins, meat, or by inhaling droplets containing the bac
Transmission from long-term reservoirs to amplifying hosts to humans is mostly by fleas (bubonic with dev of lesions)
After an uninfected flea has a blood meal from a plague infected animal;. The plague bacilli multiply in the gut of the flea,
Subsequent blood meals for the flea contain regurgitated infectious material
Plague occurs in 200 diff species of mammals
Transmission to humans can also be by aerosol or septicemic movement to lungs (pneumonic)
List the three forms of plague and identify the major clinical symptom for each.
mortality if each?
Bubonic:
Sudden, high fever
Headache
Chills
Body aches
Swollen, painful lymph nodes at the groin and armpits (buboes)
Organism filled swellings
Most common is femoral lymph node
Next most common is inguinal, axillary, cervical
Location of buboes is a function of the region of the body where an infected flea bit the person and inoculated plague bacilli into the bite
Organism enters skin through flea bite, is carried by lymphatic system to lymph nodes usually under the arms and in the groin
Organism multiplies, forms inflam abscesses in lymph nodes (buboes) which are extremely painful
Won’t kill patient in itself, usually only when progress to other stages
Classic clinical findings are fever, chills, malaise and regional buboes
Mortality is up to 50% if untreated (leads to septicemic plague)
Buboes freq drain into the bloodstream causing septicemia
Pneumonic:
Sudden pneumonia
Bloody, watery mucous
Resp failure
Occurs due to spread of bubonic or septicemic plague (vasculature in lungs) to lungs or direct involvement of the lungs via inhalation of droplets spread by an infected human
High mortality (up to 100% if untreated) that occurs rapidly (symp onset to death can be <2 days)
Highly contagious
Symps include CNS disorders such as convulsions, stupor, lack of coordination
Septecemic:
Fever, chills, body aches, severe abdom pain
Shock
Blackened skin at the extremities due to necrosis of the body
Organism enters through flea bite, profound septicemia early in disease
Can result from bubo drainage into bloodstream, but can also occur w/ no bubo formation
Rapid vascular collapse peripherally
DIC
High mortality (up to 100% if untreated)
Define the terms bubo, long term reservoirs and amplifying hosts and relate these terms to Yersinia pestis.
bubo= Swollen, painful lymph nodes at the groin and armpits
Organism filled swellings
Most common is femoral lymph node
Next most common is inguinal, axillary, cervical
Location of buboes is a function of the region of the body where an infected flea bit the person and inoculated plague bacilli into the bite
Long term reservoir=hosts that harbor organism (plague/ Y. pestis) but have no sign of disease–can be long term reservoirs (like for whole life)
Do not develop disease
Rodents like mice and voles
Spread bac to other mammals (amplifying hosts)
Amplifying hosts=become infected, have disease, die (massive die-offs is way to recog this stage)
Massive die offs occur during epidemics
Rats, ground squirrels, chipmunks, rabbits
Accidental hosts become infected via amplifying hosts (humans)
Explain why the name “Black Death” was given to the disease caused by Y. pestis.
Hemorrhaging occurs due to infection- induced DIC (disseminated IV coag) w/ resultant black splotches (septicemic plague) in the skin which caused the name black death to be given to the plague
Describe the means by which pneumonic plague may be contracted.
Become infected by receipt of organism from flea bite, handling infected animals, animal skins, meat, or by inhaling droplets containing the bac
Transmission from long-term reservoirs to amplifying hosts to humans is mostly by fleas (bubonic with dev of lesions)
After an uninfected flea has a blood meal from a plague infected animal;. The plague bacilli multiply in the gut of the flea,
Subsequent blood meals for the flea contain regurgitated infectious material
Plague occurs in 200 diff species of mammals
Transmission to humans can also be by aerosol or septicemic movement to lungs (pneumonic)
Explain why routine laboratories do not attempt to culture suspected cases of plague.
BSL category and requirements (3)
category of agent (A, B, or C)
Cultures Y. pestis
Immediately sent to labs w/ special facilities able to contain spread
Category A agent (easily transmitted, high mortality)
Req BSL-3 precautions (hosp are BSL 2, so need to contact public health dep and CDC for their labs)
BSL 3= level 2 + special clothing, controlled access, directional airflow
collection of Y. pestis specimen of interest (3)
Depends on symptom displayed by indiv
Bubonic–bubo aspirate w/ needle and syringe to withdraw fluid
Septicemic–blood
Pneumonic–sputum, throat
who expereinces K antigen interference
salmonella, shigella, yersina
shigella
who experiences HUS as a complication
E. Coli 0157:H7
exotoxin vs enterotoxin vs endotoxin
exo= shiga tox (gram pos or neg can make)
entero=Gi tox
endo= LPS gram neg tox —> shock
all enteric bac have these
which bac species and genus is H2S pos in addition to lactose negative (no color on MacConkey agar)
salmonella
what tribe needs to be ruled out as a pathogen because it is gram negative even though it is an enteric normal flora
proteeae
cholecystitis?
inflam of gallbladder due to salmonella complication
second most populous enteric genus (and most pop species from this genus) found in intestine as normal flora
klebsiella pneumoniae